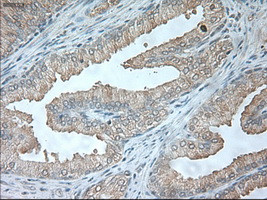
USP13 Antibody in Immunohistochemistry (Paraffin) (IHC (P))

Search
OriGene
USP13 Monoclonal Antibody (OTI4G11), TrueMAB™
{{$productOrderCtrl.translations['antibody.pdp.commerceCard.promotion.promotions']}}
{{$productOrderCtrl.translations['antibody.pdp.commerceCard.promotion.viewpromo']}}
{{$productOrderCtrl.translations['antibody.pdp.commerceCard.promotion.promocode']}}: {{promo.promoCode}} {{promo.promoTitle}} {{promo.promoDescription}}. {{$productOrderCtrl.translations['antibody.pdp.commerceCard.promotion.learnmore']}}
产品信息
TA500318
种属反应
宿主/亚型
分类
类型
克隆号
抗原
偶联物
形式
浓度
规格
纯化类型
保存液
内含物
保存条件
运输条件
靶标信息
Deubiquitinase that mediates deubiquitination of target proteins such as BECN1, MITF, SKP2 and USP10 and is involved in various processes such as autophagy and endoplasmic reticulum-associated degradation (ERAD). Component of a regulatory loop that controls autophagy and p53/TP53 levels: mediates deubiquitination of BECN1, a key regulator of autophagy, leading to stabilize the PIK3C3/VPS34-containing complexes. Also deubiquitinates USP10, an essential regulator of p53/TP53 stability. In turn, PIK3C3/VPS34-containing complexes regulate USP13 stability, suggesting the existence of a regulatory system by which PIK3C3/VPS34-containing complexes regulate p53/TP53 protein levels via USP10 and USP13. Recruited by nuclear UFD1 and mediates deubiquitination of SKP2, thereby regulating endoplasmic reticulum-associated degradation (ERAD). Also regulates ERAD through the deubiquitination of UBL4A a component of the BAG6/BAT3 complex. Mediates stabilization of SIAH2 independently of deubiquitinase activity: binds ubiquitinated SIAH2 and acts by impairing SIAH2 autoubiquitination. Has a weak deubiquitinase activity in vitro and preferentially cleaves 'Lys-63'-linked polyubiquitin chains. In contrast to USP5, it is not able to mediate unanchored polyubiquitin disassembly. Able to cleave ISG15 in vitro; however, additional experiments are required to confirm such data. [UniProt]
仅用于科研。不用于诊断过程。未经明确授权不得转售。
篇参考文献 (0)
生物信息学
蛋白别名: Deubiquitinating enzyme 13; Isopeptidase T-3; ISOT-3; Ubiquitin carboxyl-terminal hydrolase 13; ubiquitin specific peptidase 13 (isopeptidase T-3); ubiquitin specific protease 13 (isopeptidase T-3); Ubiquitin thioesterase 13; ubiquitin thiolesterase 13; Ubiquitin-specific-processing protease 13; unnamed protein product
基因别名: IsoT-3; ISOT3; USP13
UniProt ID: (Human) Q92995
Entrez Gene ID: (Human) 8975, (Dog) 478640